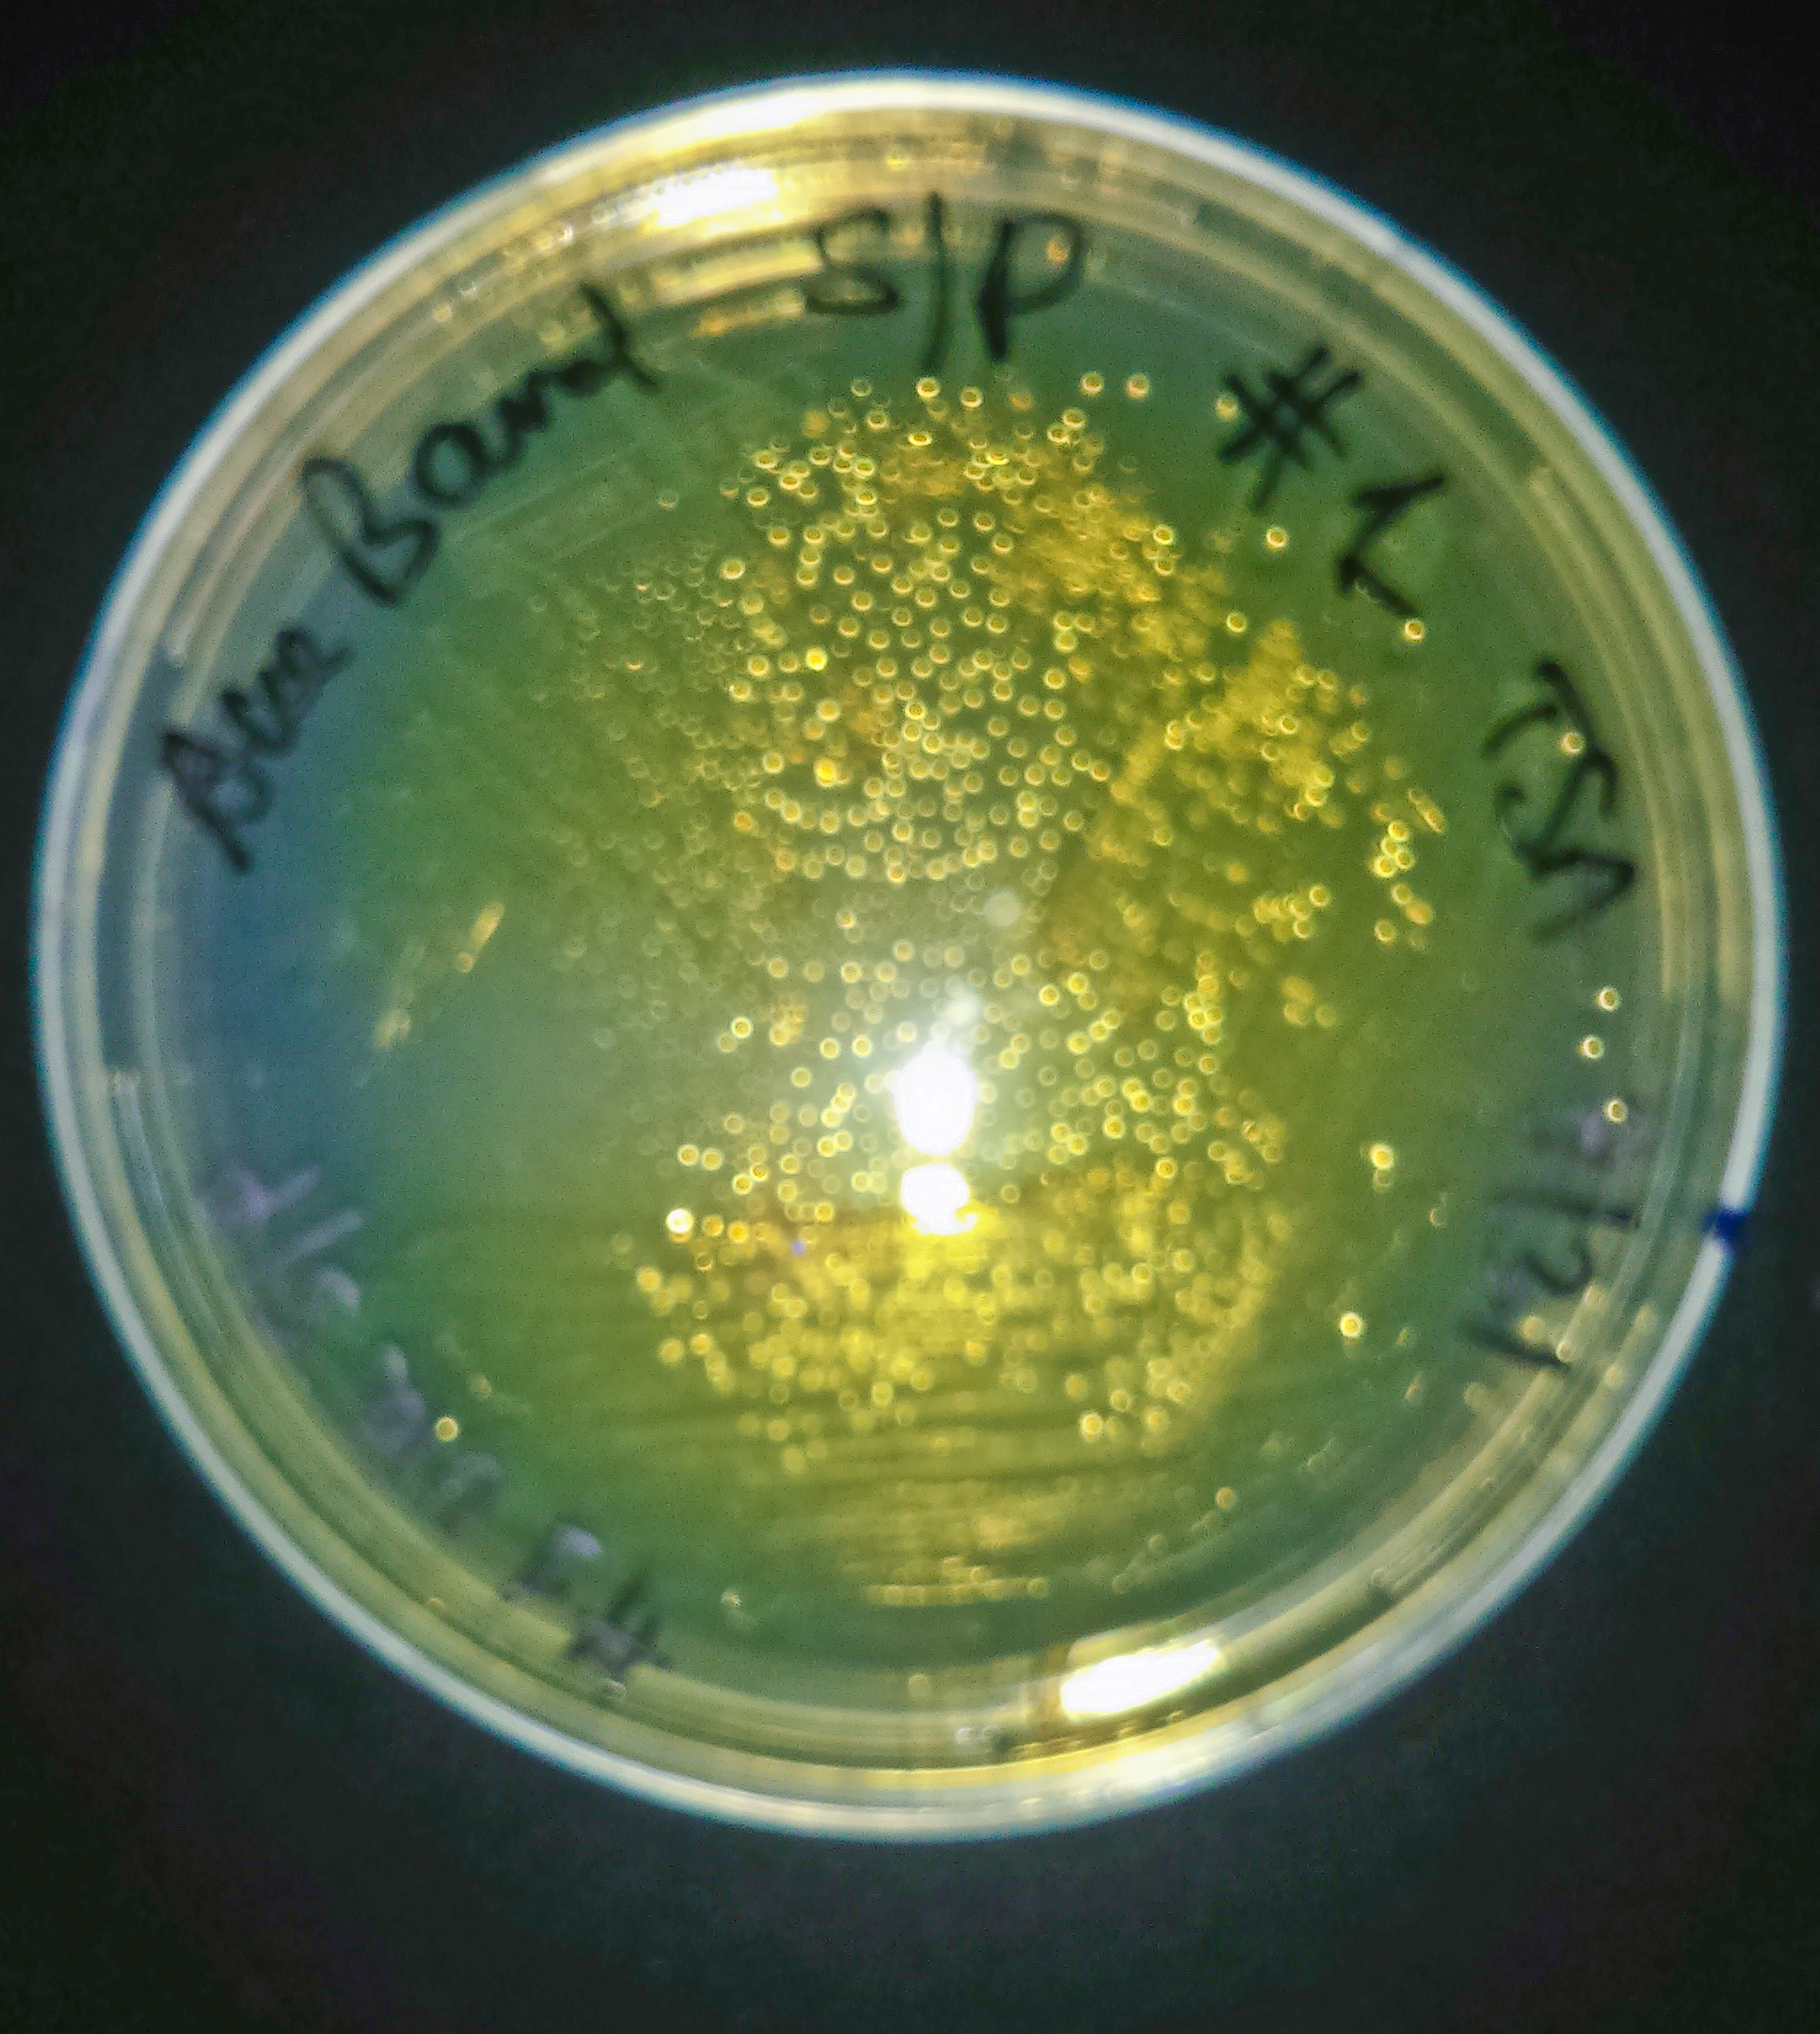

Last day of SWI was a tad more relaxed than the previous. After breakfast the four working groups presented their ideas about course implementation as either non majors or majors general biology, cellular/molecular biology, or microbiology. I was in the majors biology group, one of the largest and most diverse regarding student characteristics and type of course. For some students, this would be their first lab course; for others it would be the second or third. Some courses were planned as pure lab, others had lecture components. The non majors group was also very diverse and with the added burden or beauty of teaching students not heading to sciences. Our presentations reflected that, mainly concentrated on process skills and providing examples of approaches we thought useful, such as scaffolded graphing assignments, or a stepwise progression in poster presenting skills from critique to design, with plenty of feedback opportunities. Our group’s most popular contributions were related to quantitative analysis, with emphasis on introducing graphing and statistics applied to colony numbers and diversity. That science is indeed a collaborative process was evidenced by the fact that these ideas came from the ecologists in the group. On the other hand, the cellular/molecular bio and microbio groups presented more detailed and structured proposals, delving into rather specific areas such as materials and stock cultures, ASM guidelines, and even tentative schedules.
After that, it was Jo Handelsman’s turn to give a kind of final words and to outline strategies. She used the word “historic” and expressed hope that this workshop would indeed start a major expansion of research based science courses in the field of biology, joining others such as SEA-phages and of course GEP. We participants of this first cohort will be known from now as SWIPPs (from SWI Pilot Partners), which provoked some chuckles.
As we go home, many of us plan to pilot the course or parts of it soon, while others well implement it next Spring. Working groups of volunteers were formed to tackle tasks such as standardization of test cultures, materials, methods, sample and data collection, web page design, and social media presence.
Picture taking and lunch followed, then we returned to the lab and the pungent odor of soil microbes emanating from the incubator. My two samples, picked out as afterthoughts, looked pretty after being streaked, and I put parafilm around their edges to ship home.
“You get attached to them, the little bugs.” Unknown microbiologist, any century after the microscope.
Another treasure that I am bringing home is a Falcon tube with a brownish mass: a kombucha starter. Besides being a fermented and supposedly healthy probiotic drink, it is also a great model of a microbial ecosystem, as described in Ashley Shade‘s research. Once I knew she was in the same building, we communicated via email and then chatted in person about fermented foods and drinks. Can’t wait to plop the stuff in sugary tea and see it grow. As one of the microbiologists said to me: “you get attached to your bugs.” She was the one who found out the rules to mail biological samples, and in the afternoon we walked together to the UPS store to send our plates with the babies home. The kombucha however crossed the TSA inspection in the ziplock bag together with my contact lens fluid. I guess the tube looked like a funky container and nothing else.
I write this on the Atlanta-Orange county leg of my flight home. The four last participants in town who had to wait for a crack of dawn flight shared a great tapas dinner at a place named Barcelona Friday evening, and today we are heading back to campuses scattered all over the country. Whatever happens in one year, rest assured that something will be presented at the ASM meeting, or ASM-CUE. And materials well emerge soon: from a Yale newspaper to professional channels, we expect the word to spread.
Dear readers, would you consider implementing SWI, or other research-based science course?

Aug 04, 2013 @ 23:52:50